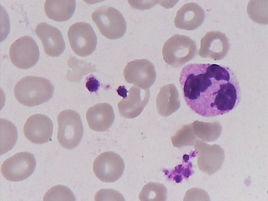
嗜血綜合徵

基本信息
嗜血細胞綜合徵可分為原發生和反應性,會伴隨有潛在疾患感染、腫瘤、免疫介導性疾病等,由於噬血細胞增多,加速了血細胞的破壞。網際網路上有2個診斷標準 1發熱;2肝脾腫大;3血細胞減少(外周血二或血三系細胞減少),其中血紅蛋白<90g/L,血小板<100 x 109/L,中性粒細胞<1.Ox109/L;4高甘油三醋血症和/或低纖維蛋白原血症;5骨髓、脾或淋巴結可見噬血細胞但無惡性表現。 I)發熱超過1周,熱峰>38.5'C;(2)肝脾大伴全血細胞減少,累計>=2個細胞系;(3)骨髓增生減少或增生異常,嗜血細胞占骨髓有核細胞>2%;(4 )肝功能異常,血乳酸脫氫酶>10 00U/L或>正常均值+3s,好像這個病打的有點濫了,找不出病因,看到幾個吞噬細胞就是 感染性嗜血細胞綜合症是一種與急性病毒感染有關的良性噬血組織細胞增生症,多發於兒童,其特點為單核-巨噬細胞增生活躍,並有明顯的吞噬紅細胞現象。患者多有明顯高熱,肝、脾和淋巴結腫大,原發病治療好後多可自愈。患者有貧血現象,白細胞明顯減少,分類可見淋巴細胞明顯增高,易見異淋。血小板常減低。骨髓多增生活躍,粒系統所占比例降低,中性粒細胞可見毒性變。幼紅系統增生多正常,淋巴系統比例亦未見明顯改變,可見異淋。單核巨噬系統增生活躍,常>10%,巨噬細胞大小為20~40微米,或更大,胞漿豐富,吞噬多個成熟紅細胞,或幼紅細胞或血小板等。巨核細胞大致正常。
其他資料
從症狀看還要排除下過敏性紫癲. 1. 結合臨床表現和實驗室檢查結果,我更傾向於嗜血細胞綜合徵,可能為病毒感染相關性,仔細看看血片能否見到異形淋巴細胞。如果比例在臨界值,你就保守一點,報“不除外嗜血細胞綜合徵,請結合臨床考慮”。 2.關於嗜血細胞綜合徵骨髓象中嗜血細胞比例的問題,我認為不能對2%認得太死,因為嗜血細胞體積較大,推片時易於推至片尾和邊緣,所以按常規體尾交界處分片法,可能比例較低,但片尾和邊緣可能較多,我認為應該縱觀全片,只要片尾和邊緣嗜血細胞明顯增多,甚至成堆分布,即使體尾交界處比例達不到2%,依然可以診斷,我就下過這樣的診斷。